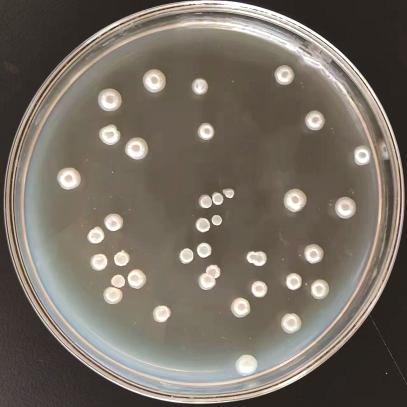

甘薯茎线虫病是影响甘薯生长发育的病害之一,田间受害薯块出现糠心现象,可使发病田块减产20%~50%
[1]。该病害在一定程度上限制了甘薯相关产业的发展。近年来,在甘薯生长过程中,针对茎线虫采取了倒茬、清除病残体、生产无病种薯和培育无病壮苗等诸多农业防治措施,但杀虫效果仍有待进一步提高
[2]。化学药剂防治是该病害防治的重要手段之一。陈昆圆等
[3]研究表明,45%三氟吡啶胺SC对甘薯茎线虫病的触杀活性和盆栽防治效果较好,虫口减退率超过50%。而长期施用化学药剂可能会使线虫产生抗药性,且可能对环境造成一定的污染。微生物杀虫剂具有安全、环保可持续、防治效果好且成本低等优点,成为当前防治甘薯茎线虫病的研究热点之一。
农作物生产不仅要求高产稳产,同时也要求品质优良。在当前生态农业发展背景下,减少化肥施用,采用生态方法促进土壤磷、钾溶解,提高有效磷、有效钾含量,对改善土壤结构,促进作物生长具有重要意义。代志等
[4]研究表明,土壤中不仅存在能够抑制和杀死有害生物的生防菌,也存在能够固定氮素,促进土壤中难溶性磷、钾释放的促生菌。孟丽媛等
[5]研究指出,按照微生物的作用机理可将其菌肥分为自生固氮菌肥料、解磷细菌肥料、解钾细菌肥料、抗生菌肥料以及复合微生物菌肥。当前研究大多集中在单一菌种的作用或多菌种复合实现菌株多功能化方面,而对于具有多种功能的微生物菌肥研究相对较少。多功能菌种能够有效解决单一菌种稳定性不高,功能单一,以及复合菌剂菌种间的拮抗作用、菌种生存条件存在差异性等问题
[6-7]。本研究以生物技术手段分离、筛选出兼具多种功能的菌种并对其进行鉴定,以获得一种应用于甘薯茎线虫病防治的多功能生物制剂(微生物肥),为防治甘薯茎线虫病的微生物菌肥研发提供参考。